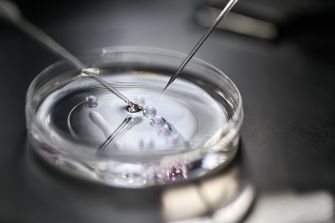
Micropipettes manipulating embryos in a petri dish, commonly used in in vitro fertilization procedures.

Nine couples in California have come together to file a joint lawsuit against in vitro fertilization provider Ovation Fertility in Newport Beach, California. The couples say that workers at the fertility clinic’s lab knowingly passed on nonviable embryos to be implanted in patients, despite knowing that the embryos were not viable. The joint lawsuit comes a week after a couple filed a similar lawsuit against the fertility clinic on their own.
The joint lawsuit explains that between Jan. 18, 2024, and Jan. 30, 2024, the nine couples underwent medical treatment to have their embryos implanted. In the days and weeks after the implants, the couples experienced the heartbreaking reality that their embryos did not result in pregnancies.
Some of the couples underwent additional medical procedures to determine if there were underlying medical issues that prevented their bodies from accepting the implants.
It was not until late February and early March that Ovation Fertility shared with physicians that there had been issues in the lab that resulted in the embryos becoming non-viable. Physicians were notified of the lab issues only after the doctors began questioning why the success rate for implantation of embryos that had been thawed during a two-week period was 0% as compared to the normal 75% success rate.
After physicians were notified about the lab issues, they were given a range of reasons why the embryos became nonviable, including issues with lab temperature levels, pH levels, carbon dioxide exposure, and other environmental factors inside the lab.
Ovation Fertility later shared a statement that explained, “This was an isolated incident related to an unintended laboratory technician error that impacted a very small number of patients. As soon as we recognized that pregnancy numbers were lower than our usually high success rates, we immediately initiated an investigation. We did not knowingly transfer nonviable embryos for implantation."
In their lawsuit, the nine couples accuse Ovation Fertility of negligence; medical battery; concealment; intentional misrepresentation; negligent misrepresentation; negligent hiring, retention, and supervision; and loss of consortium.
The complaint alleges that after the facility realized the mistake they made in the lab, they tried to conceal their mistake by “trick’ patients into signing waivers.
One of the couples, Brooke Berger, 37, and her husband, Bennett Hardy, 33, say they felt misled and duped after they worked with Ovation Fertility. They shared with ABC News that they had been struggling with infertility issues even before they began working with Ovation Fertility. However, after the physician they had been working with transferred to Ovation Fertility, they followed him to the new facility thinking they would have access to additional resources. They shared, "Our last provider, he was a small practice. They stored everything on site, but they took really good care of our embryos and we just sort of assumed that when we went to the big corporation that had all these resources that they would be probably even safer there, and I've just now learned how sort of naïve that assumption was."
The couples are seeking a trial by jury and an unspecified amount in damages.